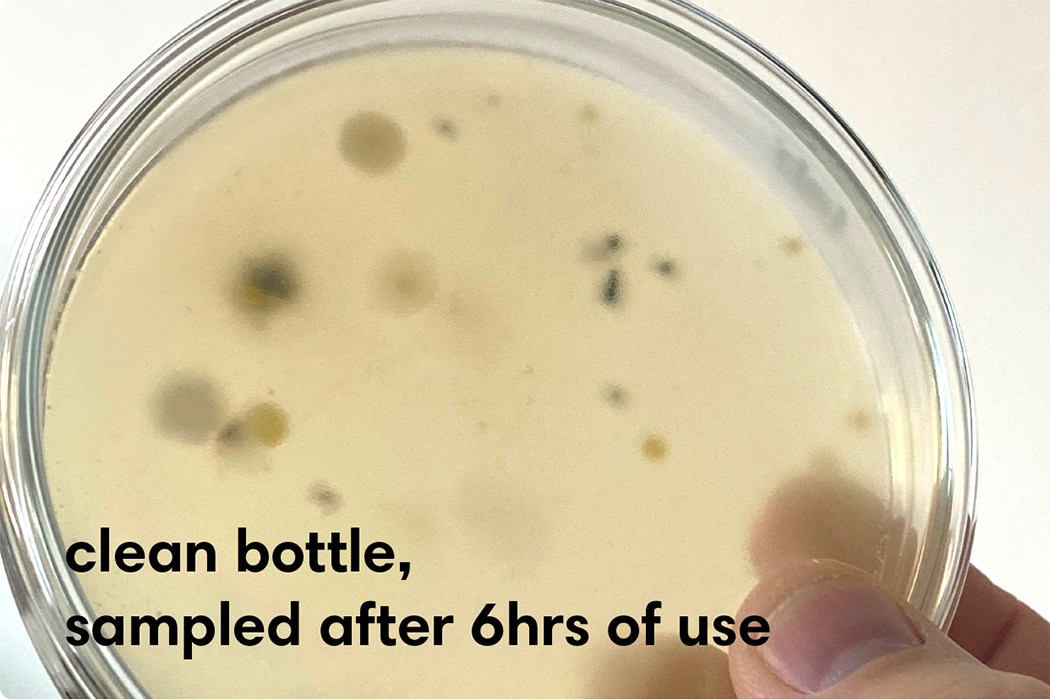
Nuvoe，Purification of water，disinfect，portable，

This work is reposted from the original designer:Nuvoe

New user?Create an account
Log In Reset your password.
Account existed?Log In
Read and agree to the User Agreement Terms of Use.

Please enter your email to reset your password
好产品
适合外观旅游的人
这个太实用了